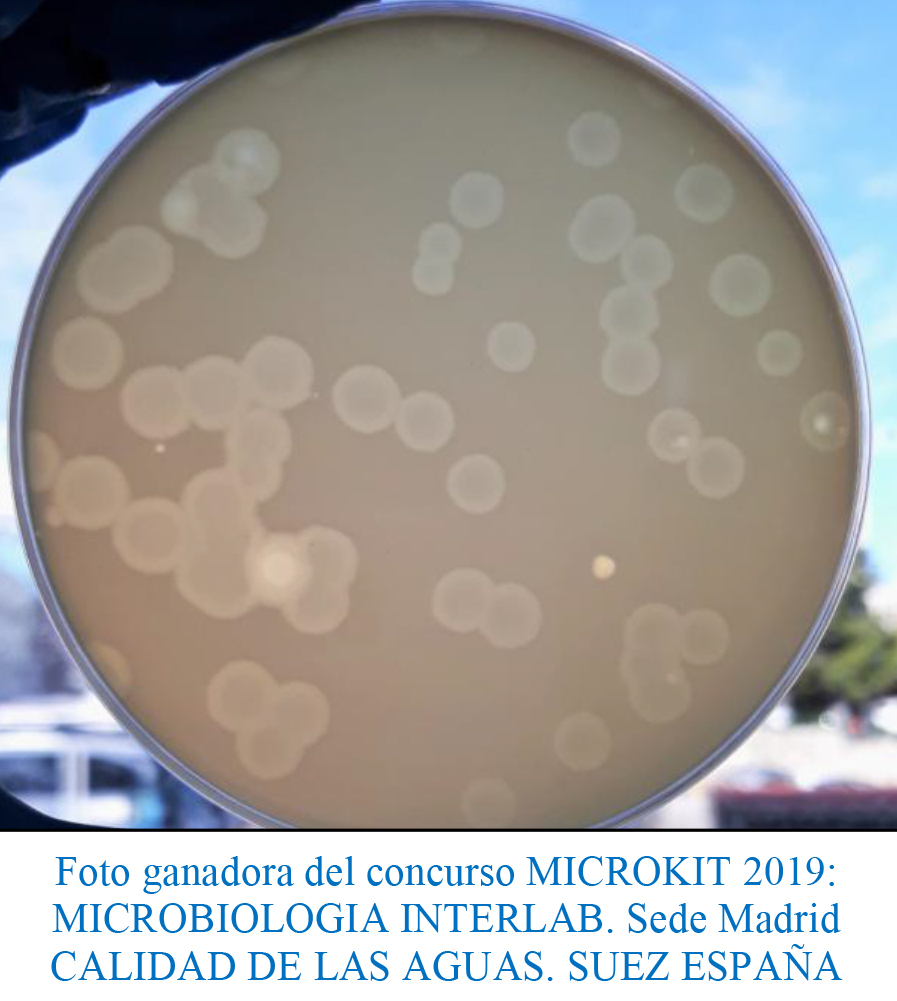

colífagos bacteriófagos Real Decreto 3/2023, medio semisólido para recuento de virus en aguas de consumo humano, 10-1-2023
colífagos bacteriófagos Real Decreto 3/2023, medio semisólido para recuento de virus en aguas de consumo humano, 10-1-2023
Detección y enumeración de bacteriófagos (Recuento de halos de lísis) ISO 10705:2001
COMPOSICIÓN
- Peptona 10,00 g
- Extracto de Levadura 3,00 g
- Extracto de carne 12,00 g
- Cloruro Sódico 3,00 g
- Carbonato Sódico 0,75 g
- Cloruro Magnésico 0,60 g
- Agar-agar 6,00 g
(Fórmula por litro) pH final: 7,2 ± 0,2
PARA USO EXCLUSIVO EN LABORATORIO. MANTENGA EL BOTE BIEN CERRADO EN LUGAR SECO, FRESCO Y OSCURO. AGITE EL BOTE ANTES DE USAR.
PREPARACIÓN
Disolver 35,1 gramos de medio en 1 litro de agua bidestilada. Calentar, agitando, hasta ebullición, para la total homogeneización. Autoclavar a 121 ºC durante 15 minutos. Preparar tubos con 2,5 ml.
PRESENTACION: DESHIDRATADO CODIGO: DMT803
SIEMBRA
Seguir las directrices de la norma ISO 10705.
bacteriófagos colífagos Real Decreto 3/2023, medio semisólido para recuento de virus en aguas de consumo humano, 10-1-2023
Usar también este mismo medio semisólido (DMT803) en Agar (DMT802) y en caldo (DMT801)
https://www.microkit.es/fichas/BACTERIOFAGOS-COLIGRAFOS-SCHOLTEN-SEMISOLID.pdf
Si desea más información sobre nuestro MEDIO BACTERIÓFAGOS-MEDIO SEMISÓLIDO MODIFICADO SCHOLTEN rellene nuestro formulario de contacto http://www.medioscultivo.com/contacto . O si lo prefiere póngase en contacto con nosotros a través de nuestro correo electrónico microkit@microkit.es o por teléfono en el nº 91-897 46 16